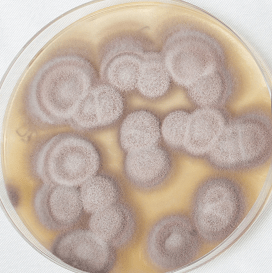

Abamectin has a strong killing effect on nematodes, but cannot kill eggs.
Paecilomyces lilacinus is an endoparasitic fungus and is an important natural enemy of some plant parasitic nematodes. It can parasitize on nematode eggs, and can also infect larvae and females. It can significantly reduce root-knot nematodes, cyst nematodes.
The combination of the two can effectively kill the larvae, adults and eggs of plant nematodes such as stem nematodes, and can also promote the growth of plants, and has a good effect on root protection, repair and rooting.